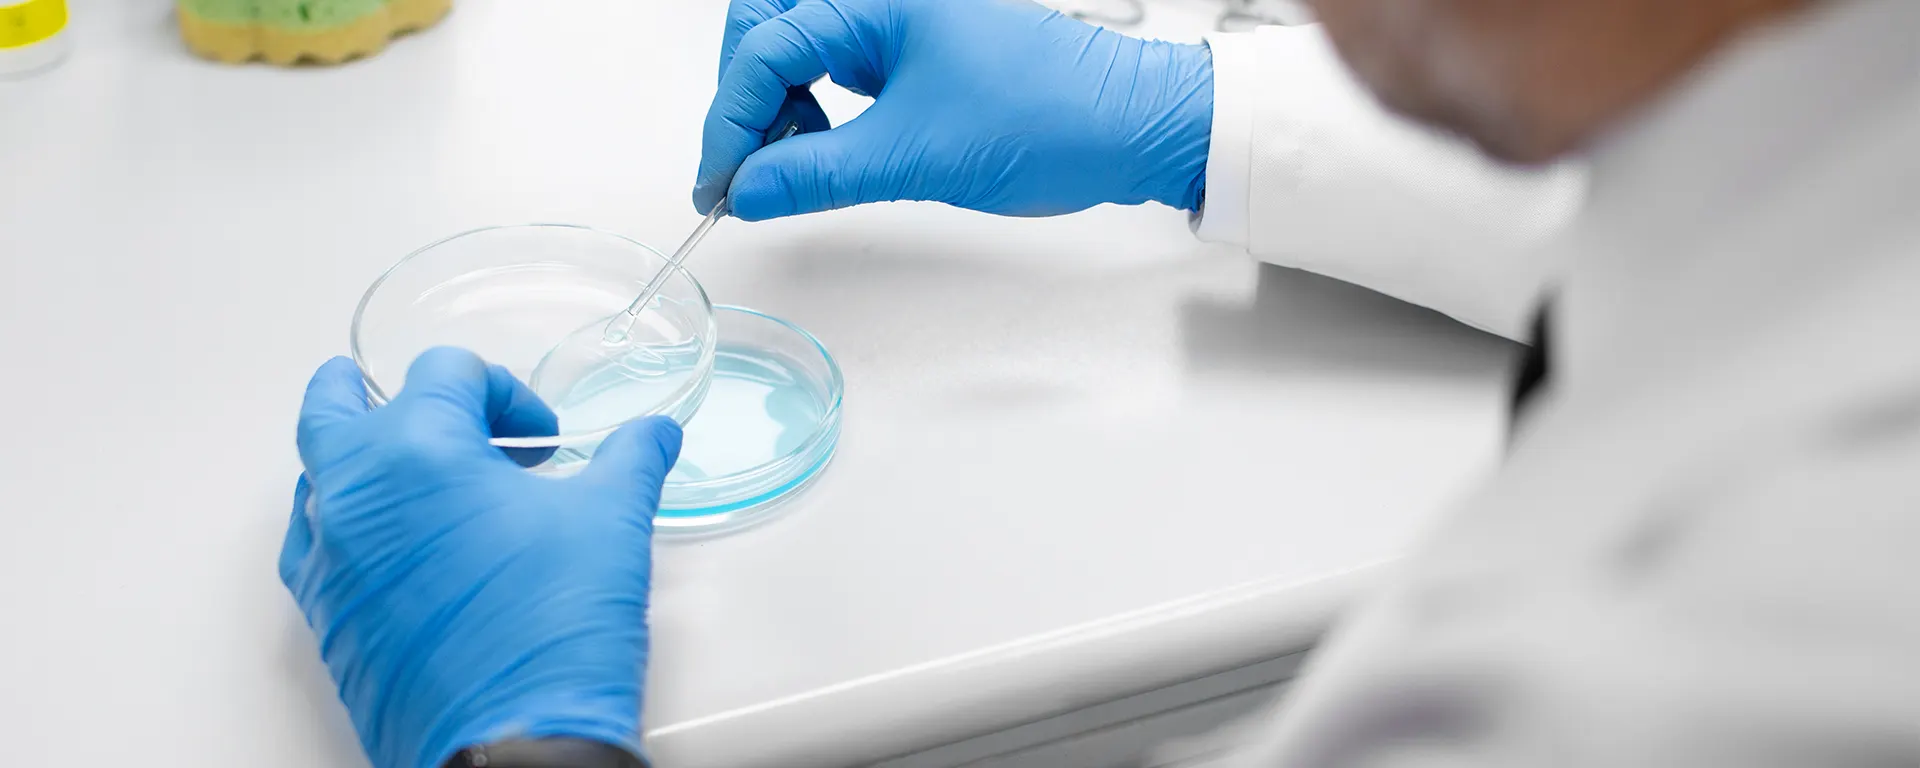
Best Testicular Sperm Extraction (TESE) in Surat

Testicular Sperm Extraction (TESE)
Turning Biological Dreams into Reality with Expert TESE Treatment for Male Infertility in Surat
Best Testicular Sperm Extraction (TESE) in Surat
Struggling with male infertility? Testicular Sperm Extraction (TESE) can help. At Devaki IVF Centre, we offer safe and effective TESE treatment in Surat to help couples conceive. Our TESE surgeon provide compassionate and effective care to help you become a father.
What is Testicular Sperm Extraction (TESE)?
TESE is a quick medical test for men who can’t have children because their semen has very few or no sperm. The doctor removes a small tissue sample from the man’s testicles (the part that makes sperm) and checks it under a microscope for healthy sperm. If they find any, the sperm can be used to help the man’s partner get pregnant using fertility treatments like IVF or ICSI.
Types of Sperm Extraction
When men have trouble having babies because of sperm problems, doctors can help by collecting sperm directly from the testicles. Here are the main ways they do this:
Type of Procedure | What It Does | Best For |
TESE (Testicular Sperm Extraction) | Takes small pieces of testicle tissue to find sperm | Men who make very few sperm |
Micro-TESE | Uses a special microscope to carefully find sperm | Men who make extremely few sperm |
PESA (Percutaneous Epididymal Sperm Aspiration) | Uses a tiny needle to get sperm from tubes near testicles | Men with blocked sperm tubes |
TESA (Testicular Sperm Aspiration) | Uses a needle to take sperm directly from testicles | Quick procedure when sperm is blocked |
MESA (Microsurgical Epididymal Sperm Aspiration) | Uses microscope to collect sperm from tiny tubes | Men with very small blockages |
The TESE Procedure: Step-by-Step
The Testicular Sperm Extraction (TESE) procedure is a surgical method used to retrieve sperm directly from the testicles in men with azoospermia (no sperm in the ejaculate). It is commonly performed for in vitro fertilization (IVF) with intracytoplasmic sperm injection (ICSI). Below is a step-by-step breakdown of the TESE procedure:
- Sleepy Medicine – You’ll get special medicine to help you sleep so you won’t feel anything.
- Tiny Cut to Help – The doctor makes a very small cut in the scrotum (the skin sac that holds the testicles).
- Finding Sperm – The doctor takes tiny bits of tissue from inside, like plucking a few grapes from a bunch.
- Sperm Search – The tissue goes to a lab, where scientists check for sperm using powerful microscopes.
- All Done – The small cut is closed with stitches that dissolve on their own. You’ll rest a bit, then go home the same day.
Benefits of Testicular Sperm Extraction (TESE)
TESE helps men who have no sperm in their semen still become fathers. Here’s why it’s helpful:
- Finds sperm when normal tests can’t – Even if semen shows zero sperm, TESE often finds some in the testicles
- Works for different problems – Helps both blocked tubes and low sperm production
- Safe and simple – Small procedure with quick recovery
- Gives hope for IVF/ICSI – Collected sperm can fertilize eggs in the lab
- Higher success – Better chance than other sperm retrieval methods